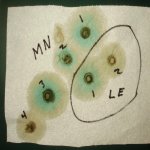
CLEANING PAD.jpg

I have recently purchased two 8mm Mausers. One is a VZ24 and the other is a Mannlicher 1904 Portuguese Verguiro. Both of these are in good shape. The bbls. looked good at purchase. I took them out this AM and they fired well enough. Got home and proceeded to clean them after firing and what a mess in the bbls. I had 24 reloads from the one vendor, they were older and the primers had a green ring around them but I was assured they were modern primers. I fired these off 4 at the time and than fired of 4 each gun new factory ammo. The factory ammo was way better than the reloads, glad to be done with them. I won't say these guns punch a single hole but with the factory ammo more or less free hand from a bench using my elbows on the bench three of 4 were within a couple inches kind of thing at 50 yards. And I wasn't trying all that hard. I'm not a great shot at the best of times.
Anyway I worked pretty hard to try to get some shine into the bbls. The bbls. were clean before firing and I might have oiled them prior to the range visit. But I had a lot of work and the bbls. aren't what I would like them to be. I used some brass wire brushes for a .38 special and one for a .30 cal and I used Hoppes oil and Pro-Stop one step cleaner and lubricant than hoppes oil. Wiping down often. The bbls. are dull, maybe a little shine and likely black in the groves.
Wondering if this is the best it is going to get? Anything else I can do? As long as the guns work OK, I'm not too worried I guess.
Thanks EH!
Anyway I worked pretty hard to try to get some shine into the bbls. The bbls. were clean before firing and I might have oiled them prior to the range visit. But I had a lot of work and the bbls. aren't what I would like them to be. I used some brass wire brushes for a .38 special and one for a .30 cal and I used Hoppes oil and Pro-Stop one step cleaner and lubricant than hoppes oil. Wiping down often. The bbls. are dull, maybe a little shine and likely black in the groves.
Wondering if this is the best it is going to get? Anything else I can do? As long as the guns work OK, I'm not too worried I guess.
Thanks EH!